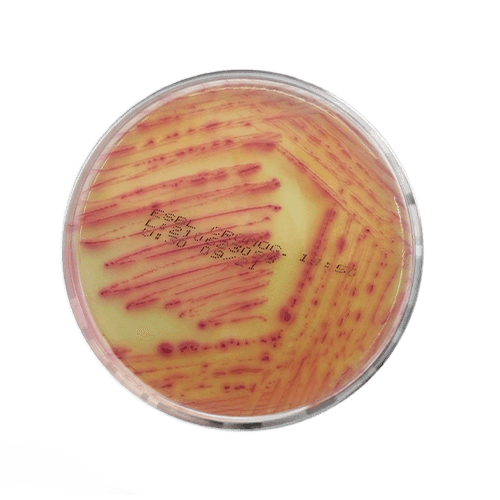

A placa de ESBL é um meio de cultura especializado desenvolvido para a detecção e isolamento de bactérias produtoras de betalactamases de espectro estendido (ESBL). Este meio é seletivo, pois contém agentes que inibem o crescimento de microrganismos não alvo, e diferencial, incorporando indicadores que facilitam a identificação com base em suas características de crescimento e resposta a antibióticos. A adição de substratos cromogênicos favorecem a visualização através da coloração diferenciada das colônias.
Este meio é muito utilizado no diagnóstico clínico e, principalmente, no controle de infecções em ambientes hospitalares.